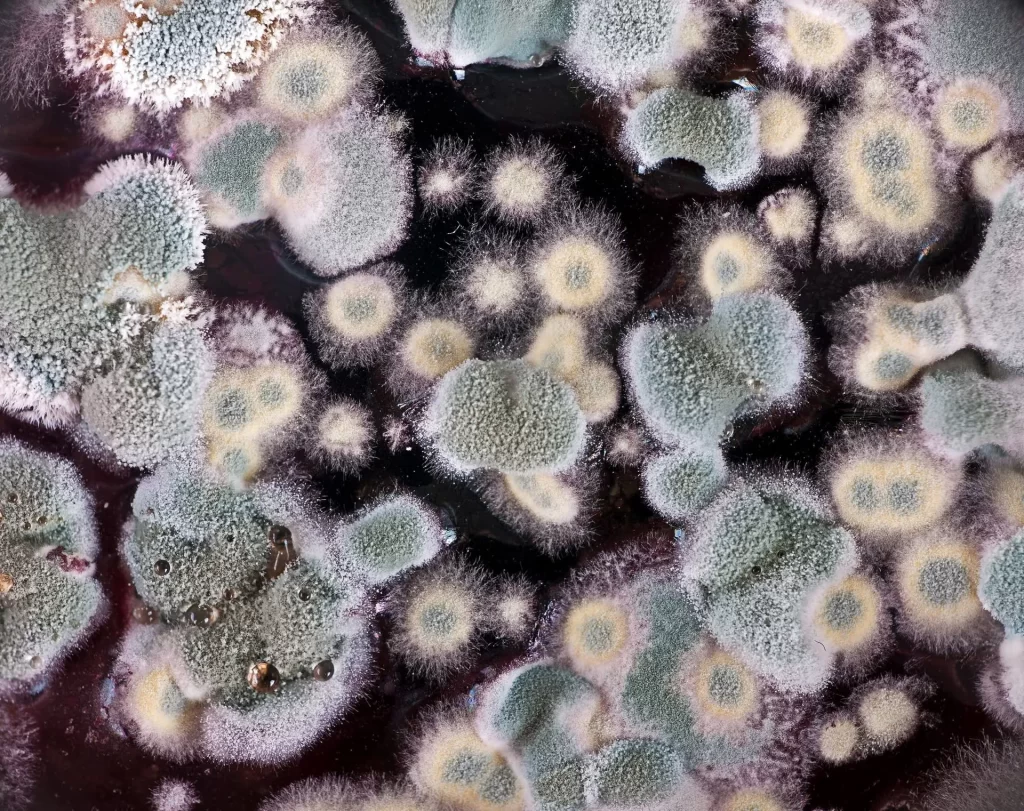

HVAC Noises You Shouldn’t Ignore
To maintain a smoothly running air conditioning system, learn to recognize potential problems by identifying noises. Ignoring these sounds may lead to increased energy bills, damage, or premature replacement of your unit. Discover five AC noises to be cautious of. Gurgling or Bubbling Sounds When the air conditioner operates, the refrigerant circulates through a closed-loop …